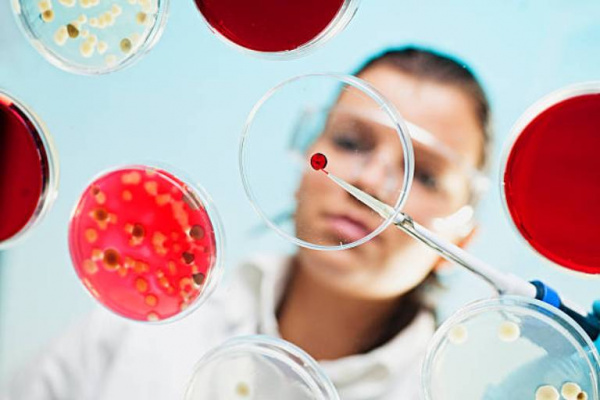
ВИЧ-инфекция полости рта

Инфекционные поражения полости рта при ВИЧ-инфекции. СПИД и полость рта.
Добавил пользователь Евгений Кузнецов Обновлено: 06.01.2026
Заражение ВИЧ ослабляет иммунную систему, делая ее уязвимой перед множеством заболеваний. Особенно часто развиваются заболевания ротовой полости. По данным Национальных институтов здоровья США (NIH) более трети всех пациентов, зараженных ВИЧ, страдают от поражений ротовой полости, которые являются прямым следствием их заболевания. Ниже описано пять внутриротовых признаков манифестации ВИЧ, на которые следует обращать внимание.
1. Ротовые бородавки
Ротовые бородавки могут возникать на любых участках ротовой полости. Такие бородавки не болезненны и похожи на выпуклые или плоские наросты, которые могут возникать в виде одного или нескольких пораженных участков. Ротовые бородавки образуются под действием вируса папилломы человека (ВПЧ) и гораздо чаще встречаются у людей, зараженных ВИЧ, чем среди остального населения, что подтверждается данными Центра по информированию о СПИДе (AETC).
Стоматолог может удалить бородавки методом криотерапии или лазером, однако они могут возникнуть вновь.
2. Волосатая лейкоплакия
Волосатая лейкоплакия сопровождается образованием белых ворсистых пятен на поверхности языка. К сожалению, такие пятна нельзя удалить с помощью зубной щетки. Кроме того, они могут быть болезненными и влиять на вкусовые ощущения.
Такой вид поражений вызывается вирусом Эпштейна-Барр – тем же вирусом, который вызывает мононуклеоз. Согласно объяснению представителей системы здравоохранения «Медицина Джонса Хопкинса», данный вирус обычно поражает людей с ослабленной иммунной системой, поэтому развитие волосатой лейкоплакии может стать первым признаком заражения ВИЧ и потребности в лечении.
3. Кандидоз полости рта
Кандидоз полости рта проявляется в виде красных пятен или белого налета, образующихся на слизистой оболочке языка и ротовой полости. На первый взгляд его признаки аналогичны признакам волосатой лейкоплакии, однако кандидозные поражения поддаются удалению. Помните, что при этом может появляться кровоточащая рана.
Кандидоз полости рта вызывается грибком рода Candida, который, согласно NIH, в малых количествах присутствует в полости рта каждого человека. Здоровая иммунная система удерживает размножение грибка под контролем, а у людей с ВИЧ контроль над размножением грибка может быть потерян. Кандидоз поддается лечению противогрибковыми средствами, однако позднее возможен рецидив.
4. Афтозный стоматит
Афтозный стоматит является очень распространенным заболеванием и проявляется на слизистой оболочке щек, губ и даже языка в виде круглых или овальных язв с белой серединой и красными краями. Такие язвы могут вызывать неприятные ощущения при раздражении их пищей или концентрированными напитками, и их полное заживление может занять до 15 дней, согласно данным Центра здоровья при Мичиганском университете.
Для афтозного стоматита отсутствует официально признанный метод лечения, однако стоматолог может назначить лекарственные средства, способные облегчить симптомы на то время, пока язвы заживают сами собой. Если у вас часто образуются афтозные язвы, следует поговорить с лечащим врачом о том, возможно ли скорректировать план лечения ВИЧ-инфекции.
5. Заболевания десен
Заболевания десен развиваются в результате скопления бактерий вдоль линии десен, что происходит при недостаточном соблюдении правил гигиены ротовой полости. Бактерии раздражают десны, вызывают их покраснение и опухание, и при отсутствии лечения десны становятся достаточно болезненными. У пациентов, зараженных ВИЧ, заболевания десен развиваются быстрее, чем у пациентов со здоровой иммунной системой, и воспаление может стать хроническим.
При тщательном уходе за здоровьем ротовой полости заболевания десен со временем излечиваются. Если такой меры оказывается недостаточно, стоматолог может дополнительно прописать противомикробный ополаскиватель, такой как Colgate® Periogard®.
ВИЧ поражает весь организм, и ротовая полость – не исключение. Внутриротовые признаки заражения ВИЧ появляются очень часто, поэтому, если вы заражены ВИЧ, внимательно отслеживайте изменения состояния ротовой полости и обращайтесь к стоматологу сразу же, как только заметите какие-нибудь поражения, требующие лечения.
ВИЧ-инфекция полости рта
ВИЧ-инфекция полости рта - патологические изменения органов полости рта, наблюдающиеся у инфицированных вирусом иммунодефицита пациентов. При вторичном иммунодефиците начинается активное размножение условно-патогенной и патогенной флоры. Это приводит к развитию инфекционно-воспалительных, дегенеративных и онкологических процессов в полости рта: гингивита, пародонтита, хейлита, вирусных и грибковых поражений, саркомы Капоши и др. Диагностика ВИЧ осуществляется лабораторными методами и направлена на обнаружение в крови самого вируса, антител к нему и оценку состояния клеточного звена иммунной системы. Эффективное лечение на сегодняшний день не разработано, основой терапии являются антиретровирусные препараты.

Общие сведения
Причины ВИЧ-инфекции полости рта
Вирус поражает клетки-хелперы Т4 субпопуляции лимфоцитов и разрушает систему клеточного иммунитета. Ткани полости рта одними из первых теряют резистентность к оппортунистической и патогенной флоре. Чаще всего они поражаются грибком Candida albicans, вирусом простого герпеса, вирусом Эпштейна-Барр, папилломавирусами. Бактериальные инфекции вызываются ассоциациями возбудителей (анаэробы, стрепто- и стафилококки). Среди представителей анаэробной флоры лидируют фузобактерии, спирохеты, бактероиды и пептострептококки. Начинается активная пролиферация возбудителей, но на фоне подавления Т-звена иммунитета организм не может оказать сопротивления инфекции. Для пациентов с ВИЧ характерна постоянная смена стадий ремиссии и рецидива, прогрессирующее ухудшение состояния, нарастание клинической симптоматики и постепенное формирование полного синдрома необратимого вторичного иммунодефицита с летальным исходом.
В стоматологии клинические формы ВИЧ в полости рта разделяются на 3 группы, исходя из степени предположительной связи с инфицированием. К первой группе относятся патологические процессы, наиболее тесно связанные с вирусом иммунодефицита (кандидоз, волосатая лейкоплакия, ВИЧ-гингивит, язвенно-некротический гингивит, ВИЧ-пародонтит, саркома Капоши, нон-Ходжскинская лимфома). Вторую группу составляют поражения, в меньшей степени ассоциированные с ВИЧ (атипичные язвы, идиопатическая тромбоцитопеническая пурпура, патология слюнных желез, вирусные инфекции). В обширную третью группу входят поражения, которые могут быть при ВИЧ-инфекции, но не связаны с ней.
Симптомы ВИЧ-инфекции полости рта
Известны многочисленные клинические проявления ВИЧ-инфекции в полости рта. У 75% пациентов диагностируется кандидоз, чаще всего в псевдомембранозной форме. При осмотре выявляется беловато-серый творожистый налет на внутренней поверхности щек, неба, языка и десен. При снятии налета шпателем обнажается изъязвленная поверхность. Реже встречается гиперпластическая форма, характеризующаяся наличием плотных белых очагов, спаянных со слизистой оболочкой, и атрофическая (эритематозная), при которой наблюдаются красные пятна без налета. Пациентов беспокоит чувство жжения.
Следующей распространенной патологией является герпетический гингивостоматит. Его отличают многочисленные пузырьковые высыпания по всей слизистой оболочке и вокруг рта. После вскрытия пузырьков образуется поверхность с очагами эрозий. При волосатой лейкоплакии обнаруживаются белые складки или ворсинки на слизистой, плотно спаянные с окружающими тканями. Чаще всего они располагаются по краю языка. Пациент может жаловаться на легкое жжение и боль. Заболевание встречается в 98% случаев инфицирования вирусом иммунодефицита. Еще одной распространенной формой ВИЧ в полости рта является язвенно-некротический гингивостоматит. Заболевание начинается с кровоточивости десен и постепенно прогрессирует, приводя к разрушению тканей периодонта вплоть до остеомиелита.
Если при осмотре выявляется сыпь с болезненными розовыми, фиолетовыми, красными пятнами или узелками на слизистой оболочке твердого неба, можно думать о саркоме Капоши. Она представляет собой злокачественную лимфангиому. Благодаря достижениям современной терапии сейчас в клинической практике саркома Капоши встречается гораздо реже. Помимо этого, существует целый ряд патологических процессов со стороны органов полости рта, указывающих на наличие вируса ВИЧ (хейлит, глоссит, язвы, телеангиэктазии и др.), но их распространенность менее велика.
Диагностика и лечение ВИЧ-инфекции полости рта
Главным диагностическим инструментом ВИЧ-инфекции являются лабораторные данные. С момента инфицирования и до появления клинически значимых симптомов может пройти несколько лет, но даже при отсутствии жалоб пациент является потенциально опасным и служит источником заражения для других людей. При лабораторной диагностике используют реакцию ПЦР для выявления РНК вируса, метод иммунного блоттинга для обнаружения антител к отдельным антигенам, обнаружение антител к ВИЧ методом иммуноферментного анализа и исследование иммунного статуса. При необходимости исследуют кровь пациента на наличие антител к вирусу простого герпеса, цитомегаловирусной инфекции, токсоплазме и т. д.
При подозрении на ВИЧ необходимо проводить дифференциальную диагностику с такими заболеваниями как истинная лейкоплакия, лейкоплакия курильщика, контактные аллергические реакции, гиперпластический кандидоз, красный плоский лишай. При изучении анамнеза важно выявить причины, которые могли бы повлиять на работу иммунной системы, например, прием цитостатиков и кортикостероидов. Необходимо учитывать профессиональные и социальные особенности пациента, его образ жизни.
Терапия ВИЧ базируется на комплексной программе, основой которой являются антиретровирусные препараты: ингибиторы обратной транскриптазы (ламивудин, диданозин, зидовудин) и ингибиторы протеазы ВИЧ (саквинавир, нелфинавир, индинавир). Для лечения сопутствующих ВИЧ-ассоциированных состояний, вызванных размножением условно-патогенной и патогенной флоры, используются антибиотики широкого спектра действия, противогрибковые и противовирусные препараты, средства, подавляющие рост анаэробной флоры и противоопухолевые препараты (циклофосфан, метотрексат). Важным звеном терапии ВИЧ является специфическая иммунотерапия для укрепления Т-клеточного иммунитета (ВИЧ-1-специфический иммуноглобулин, смесь моноклональных антител).
Прогноз и профилактика ВИЧ-инфекции полости рта
При обнаружении заболевания на ранней стадии и своевременном начале терапии прогноз относительно благоприятный. Комплексные меры, замедляющие размножение вируса, позволяют поддерживать нормальный иммунный ответ и противостоять оппортунистическим заболеваниям.
Профилактика ВИЧ-инфекции сводится к тщательному контролю трех путей передачи вируса. Чаще всего возбудитель передается половым путем, поэтому при любых контактах необходимо пользоваться качественными барьерными методами контрацепции. Для профилактики парентеральной передачи возбудителя в медицинских учреждениях и организациях, оказывающих косметологические и эстетические услуги, должны тщательно соблюдаться все санитарно-эпидемические требования к асептике и антисептике. Для предотвращения вертикального пути передачи (от матери к ребенку) необходимо тщательное обследование беременных женщин на ВИЧ и, при наличии положительного результата, тщательное наблюдение за будущей мамой.
Оппортунистические инфекции
Оппортунистические инфекции – это большая группа инфекционных заболеваний, которые развиваются у пациентов с различными типами иммунодефицитов и нехарактерны для людей с нормальным иммунным статусом. Патологии поражают любую систему органов и вызывают соответствующую симптоматику. К общим клиническим проявлениям относят длительный субфебрилитет, лимфаденопатию, астенический синдром. Диагностика оппортунистических инфекций включает серологические, молекулярно-генетические, бактериологические и другие методы детекции патогенных возбудителей. Программы лечения сочетают длительную этиотропную терапию с методами иммунокоррекции.
МКБ-10


Проблема оппортунистических инфекций (ОПИ) становится все более актуальной, что вызвано ростом числа ВИЧ-инфицированных людей, разработкой эффективных, однако агрессивных методов лечения онкопатологии. При этом многие люди являются бессимптомными носителями возбудителей ОПИ: 60% инфицированы цитомегаловирусом, 90% – герпесвирусами 1 и 2 типов, около 30% – токсоплазмой. Учитывая клинический полиморфизм и отсутствие специфических симптомов, диагностика и лечение оппортунистических болезней представляет серьезную мультидисциплинарную проблему.
Причины
Для манифестации оппортунистических инфекций необходимо заражение патогенным микроорганизмом: вирусом, бактерией, грибком или простейшим. Известно более 20 типичных возбудителей ОПИ, в современной инфектологии этот перечень постоянно дополняется. Болезнь возникает при активации латентного очага, реже выступает следствием текущего заражения. Первостепенную важность играет нарушение иммунного статуса вследствие следующих патологий:
- ВИЧ-инфекция. Самая частая причина, поскольку на определенном этапе снижения числа CD4-клеток ОПИ развиваются у каждого больного. Инфекционные болезни используются для диагностики заражения ВИЧ и определения стадии заболевания, поэтому в данном контексте они называются СПИД-ассоциируемыми или СПИД-индикаторными патологиями.
- Злокачественные новообразования. Патофизиология любого опухолевого процесса предполагает угнетение собственной иммунной системы пациента и снижение ее ответа на чужеродные агенты. При этом уменьшается число Т-клеток, угнетаются процессы фагоцитоза. Проблема наиболее выражена при гемобластозах – лейкозах и лимфомах.
- Хроническая соматическая патология. Угнетение активности клеточного и гуморального иммунитета происходит при эндокринных заболеваниях (сахарный диабет, гипотиреоз), почечной недостаточности, тяжелых воспалительных патологиях ЖКТ.
- Ятрогенные факторы. Применение цитостатиков и других видов иммуносупрессоров является важным предиктором развития оппортунистических инфекций. Подобная ситуация наблюдается в группе пациентов после лучевой терапии, трансплантации органов и костного мозга.
- Первичные иммунодефициты. В эту группу относят все виды иммунной недостаточности, которые имеют генетический характер или возникают внутриутробно под влиянием тератогенов. Они манифестируют в раннем детском возрасте, проявляются затяжными оппортунистическими болезнями, которые с трудом подаются терапии.
Патогенез
Хотя возбудители оппортунистических инфекций таксономически неоднородны, в развитии заболеваний большую роль имеют общие особенности их патогенности и вирулентности. К свойствам микроорганизмов, вызывающих ОПИ, относят возможность длительного и даже пожизненного персистирования в организме человека, внутриклеточное паразитирование, склонность к поражению клеток моноцитарно-макрофагальной системы.
Инфекции активизируются при иммунодефицитах любой этиологии и склонны к хроническому течению с периодическими обострениями, поражением жизненно важных органов. Для оппортунистических болезней характерна лимфогенная и гематогенная диссеминация микроорганизмов, образование эктопических очагов. Собственный иммунитет пациента не способен оказать должное сопротивление инфекционному агенту, лекарственные средства не всегда эффективны.
Сложность и опасность оппортунистических инфекций заключается еще и в том, что они способны подавлять естественный иммунитет. В последние годы говорят о возможности пожизненной иммуносупрессии при персистировании герпесвирусов. Таким образом, формируется порочный круг, когда иммунодефицит провоцирует активацию возбудителей ОПИ, которые усугубляют явления иммунной недостаточности и потенциируют дальнейшие полиорганные нарушения.

Классификация
Единой систематизации оппортунистических инфекций на сегодня не существует. Условно возбудителей объединяют в 3 группы: патогены, которые поражают лиц с нарушениями иммунитета и здоровых людей; микробы, встречающиеся только при иммунодефицитах; вакцинные штаммы микроорганизмов. Общепринятой является классификация ОПИ согласно типу возбудителя:
Симптомы оппортунистических инфекций
В инфектологии выделяют общую группу клинических признаков, которая встречается при любом варианте ОПИ. Наиболее типичным симптомом признан длительный субфебрилитет, которые возникает без видимой причины и беспокоит пациента больше 1 месяца. Нередко повышение температуры возникает после перенесенного ОРВИ или кишечной инфекции, которые выступают пусковым фактором активации оппортунистического заболевания.
Вторым настораживающим симптомом считается лимфаденопатия – увеличение лимфатических улов. Чаще всего в процесс вовлекается лимфоидная ткань шейно-подчелюстной, подмышечной и паховой зоны. Лимфоузлы достигают диаметра около 1 см, имеют плотноэластическую консистенцию, не спаяны с окружающими тканями и безболезненны при ощупывании.
Третью группу общей симптоматики оппортунистических инфекций составляет астенический синдром. Он включает слабость, повышенную утомляемость, снижение переносимости умственных и физических нагрузок. Зачастую пациенты жалуются на ночную потливость, головокружения и головные боли, нарушения сна. При длительном существовании таких признаков наблюдается когнитивная дисфункция, эмоциональная подавленность, стойкое снижение работоспособности.
Пациента с иммуносупрессией должен насторожить кашель и одышка – типичные признаки туберкулеза и пневмоцистной пневмонии (ПЦП), снижение остроты зрения – возможное проявление цитомегаловирусного ретинита, длительно сохраняющаяся диарея – признак криптоспоридиоза, микроспоридиоза. Жжение и сухость полости рта в комбинации с эрозиями и белыми налетами на слизистых указывают на орофарингеальный кандидоз.
Оппортунистические болезни не имеют четко выраженного тропизма. Один и тот же вид возбудителя может вызывать миокардит, плеврит, артрит, менингит и другие нозологические формы. Зачастую они имитируют симптомы хронических соматических заболеваний, с которыми пациенты длительно и безрезультатно посещают врачей разных специальностей. Исключение составляет пневмоцистоз, который в основном поражает легкие с развитием ПЦП.
Осложнения
Оппортунистические инфекции – тяжелые и потенциально смертельные заболевания. Среди пациентов с терминальными стадиями ВИЧ-инфекции ОПИ составляют 90% в структуре летальности, оставшиеся 10% приходятся на саркому Капоши, лимфомы и прочие неинфекционные последствия СПИДа. Смертность при церебральном токсоплазмозе составляет около 33%, при криптококковом менингите – 20-30%, при пневмоцистной пневмонии – 10-20%.
Особую тревогу вызывает сочетание нескольких видов оппортунистических заболеваний у одного пациента. Микробные ассоциации более характерны для позднего периода и хронического течения основной патологии, вызвавшей иммунодефицит. Сочетанное инфицирование типично для иммунокомпрометированных пациентов, пребывающих на стационарном лечении: у 40-50% больных в послеоперационном периоде, у 70-80% при перитонитах и плевритах.
Распространение оппортунистических инфекций негативно сказывается на репродуктивном здоровье населения. Они обуславливают многие случаи самопроизвольного прерывания беременности, эмбриопатий и фетопатий, задержки внутриутробного развития. Дети, рожденные от матерей с ОПИ, находятся в группе риска развития заболеваний новорожденных, перинатальных энцефалопатий.

Диагностика
Обследование пациентов проводится мультидисциплинарной командой врачей, в которую входят врач-инфекционист, иммунолог, онколог и другие узкопрофильные специалисты. Большое клиническое значение имеет выяснения времени и условий появления симптоматики, характера течения заболевания, наличия факторов риска иммунодефицитных состояний. Для подтверждения оппортунистических инфекций проводятся следующие методы диагностики:
- Инструментальная визуализация. С учетом ведущей клинической симптоматики выполняется рентгенография органов грудной клетки и живота, УЗИ брюшной полости, КТ или МРТ головного мозга. При необходимости назначается бронхоскопия, ЭФГДС и колоноскопия, люмбальная пункция. По возможности у больных с иммуносупрессией избегают инвазивных методов диагностики.
- Серологическое тестирование. Клинически значимым для острого процесса или обострения латентной инфекции является нарастание титров антител в 4 и более раза при РСК. Для определения давности заражения, особенно для ЦМВ и других герпесвирусов, определяют авидность антител. Также проводится ИФА на антитела IgM.
- ПЦР-диагностика. Молекулярно-генетический метод остается «золотым стандартом» определения большинства инфекций. Для его проведения используют разные типы биоматериала. Благодаря высокой чувствительности ПЦР обнаруживает даже единичные копии оппортунистических возбудителей в образце.
- Микробиологические посевы. Для выращивания микроорганизмов применяются специальные культуральные среды с учетом предполагаемого возбудителя. При получении колоний патогенов их тестируют на чувствительность к противомикробным препаратам, чтобы правильно подобрать лечение.
- Иммунограмма. Для диагностики клеточного иммунодефицита важную роль играет количество разных типов Т-лимфоцитов, соотношение CD4/CD8 клеток – иммунорегуляторный индекс. Гуморальное звено иммунитета оценивается по уровню CD19 (маркера В-лимфоцитов), концентрации разных классов иммуноглобулинов.
Лечение оппортунистических инфекций
В процессе лечения практикующие инфекционисты сталкиваются с такими нюансами, как множественная лекарственная устойчивость патогенов, гетерогенность популяции возбудителей, низкая активность естественных иммунных факторов. Основу терапии составляет прием этиотропных противомикробных препаратов: антибиотиков, антимикотиков, противопротозойных и противовирусных. Лечение ОПИ имеет ряд особенностей:
- в основном назначаются комбинации из 2-3 препаратов для повышения их эффективности;
- продолжительность противомикробной терапии повышается в 1,5-2 раза и более в сравнении с лечением инфекционных болезней у иммунокомпетентных лиц;
- при подборе терапии ориентируются не только на клиническую картину болезни, но и на текущий иммунный статус пациента;
- при вирусных инфекциях обязательно назначаются этиотропные препараты, тогда как у людей без иммуносупрессии противовирусные средства используют только по показаниям.
Для успешного лечения ОПИ требуется максимально возможное восстановление иммунной функции. В группе пациентов с ВИЧ-инфекцией назначаются протоколы антиретровирусной терапии (ВААРТ), чтобы повысить число CD4-клеток и улучшить отдаленные прогнозы. При ведении онкологических больных используются персональные схемы иммуномодуляторов, экспериментальные направления иммунотерапии и регенеративной медицины с применением стволовых клеток.
Прогноз и профилактика
Течение любой инфекции на фоне иммуносупрессии является сложным и непредсказуемым, однако усовершенствованные протоколы лечения позволяют достичь стойкой ремиссии или даже полного излечения. К прогностически неблагоприятным факторам относят пожилой и старческий возраст, неправильно подобранную терапию, невозможность проведения иммунокоррекции основного заболевания.
При иммунодефицитах показана первичная медикаментозная профилактика оппортунистических инфекций. Применяют сульфаниламиды, макролиды‑азалиды, противогрибковые средства. При положительной пробе Манту или недавнем контакте с больным туберкулезом назначается химиопрофилактика сроком на 6 месяцев. Также пациентам рекомендовано строго соблюдать противоэпидемические меры, в периоде резкой иммуносупрессии необходимо пребывание в стерильных боксах.
3. Клинические особенности сочетанных оппортунистических инфекций (обзор)/ В.В. Шкарин, Н.В. Саперкин// Медицинский альманах. – 2017. – №4.
4. Оппортунистические инфекции: проблемы и перспективы/ Под общ. ред. проф. Ю.В. Редькина, О.А. Мирошника, В.В. Лобова. – 2002.
Поражение ЛОР-органов при ВИЧ-инфекции
Поражение ЛОР-органов при ВИЧ-инфекции – группа патологий, развивающихся на фоне иммунной недостаточности, спровоцированной вирусом иммунодефицита человека. Самыми распространенными клиническими симптомами являются герпетическая сыпь, синюшные и багровые пятна, глубокие язвы кожи и слизистых оболочек, белые налеты, творожистые выделения изо рта, носа и слухового канала, синдром интоксикации. Диагностика направлена на определение ВИЧ-инфекции с помощью иммуноблоттинга, ИФА, ПЦР. Лечение состоит из антиретровирусной, антибактериальной, противовирусной и антимикотической терапии, симптоматических мероприятий.
Поражение ЛОР-органов при ВИЧ-инфекции встречается в 75-85% случаев. В общей сложности в мире насчитывается порядка 35 млн. человек, инфицированных ВИЧ. Отоларингологические патологии на фоне иммунодефицита статистически чаще диагностируются среди представителей мужского пола в возрасте от 18 до 45 лет. Наиболее распространенная форма – кандидоз ротовой полости, который в 50-90% становится первичным проявлением ВИЧ-инфекции. Среди бластоматозных патологий самым частым поражением ЛОР-органов является саркома Капоши. Общий показатель летальности при подобных заболеваниях составляет 45-60%. Основные причины смерти – бактериальные внутричерепные осложнения и сепсис.
Причины поражения ЛОР-органов при ВИЧ
Причина развития этой категории поражений – вирусы иммунодефицита человека 1 или 2 типа, представители семейства Retroviridae. Наиболее распространены вирионы 1-го типа группы М. Возможные механизмы инфицирования – половой, вертикальный, парентеральный, инъекционный, грудное вскармливание. Источником заражения является инфицированный человек. Самый частый путь передачи вируса – половой контакт, что обусловлено большим количеством вирусных РНК, содержащихся в семенной жидкости и вагинальном секрете. К группе риска относятся гомосексуалисты, инъекционные наркоманы и лица, которым ранее проводилось переливание крови. Развитие оппортунистических патологий происходит при сопутствующем инфицировании бактериями, грибками, вирусами и их комбинациями. При недостаточности иммунитета инфекционные агенты получают возможность бесконтрольного размножения с последующим проникновения вглубь тканей.
При инфицировании ВИЧ проникает в составляющие иммунной системы, имеющие специфический маркер CD4: Т-хелперы, моноциты, макрофаги, дендритные и микроглиальные клетки. В их цитоплазме вирус освобождает свою РНК, вживляя ее в клеточную ДНК. Изменившаяся ферментативная активность постепенно приводит к гибели клеток. Снижение уровня CD4 становится причиной потери цитотоксической активности лимфоцитов CD8. В нормальных условиях последние отвечают за контроль над бактериальными, вирусными, грибковыми агентами и мутировавшими клетками. Таким образом, патогенные и условно-патогенные агенты, проникая в полости ЛОР-органов, не встречают адекватного иммунного ответа и вызывают развитие заболевания.
В список основных поражений ЛОР-органов при ВИЧ-инфекции входят следующие патологии:
- Микотические поражения. К ним относятся кандидоз и гистоплазмоз. Кандидоз развивается при инфицировании грибом Candida albicans, поражает полость рта, глотки и наружного уха. Гистоплазмоз проявляется разрастанием ретикуло-эндотелиальных структур, возбудителем является Histoplasma capsulatum. При диссеминированной форме приводит к язвенным поражениям глотки, неба, кожных покровов.
- Бактериальные инфекции. В условиях ВИЧ-инфекции часто появляются некротические изменения слизистых оболочек носа, внутренней поверхности щек, гортани, глотки, миндалин; возникают абсцессы перегородки носа с последующей перфорацией четырехугольного хряща; формируются или обостряются хронические тубоотиты, синуситы неспецифической бактериальной этиологии. Реже выявляются специфические заболевания: хламидийные и гонококковые фарингиты, сифилитический или туберкулезный отит, фарингит, ларингит.
- Герпес-инфекции. Основной возбудитель – вирус простого герпеса человека (Herpes simplex). Проявляется высыпаниями на коже и слизистых оболочках в виде везикул, герпетической лихорадкой. Несколько реже встречается опоясывающий лишай, а также его специфическая клиническая форма – синдром Ханта, обусловленные вирусом Varicella-zoster.
- Саркома Капоши. Злокачественная сосудистая опухоль, которая способна поражать мягкое небо, небные миндалины, внутреннюю поверхность щек, гортань, глотку. Характеризуется формированием большого количества кровеносных сосудов с аномальным расширением капилляров, что становится причиной образования многочисленных полостей.
Симптомы поражения ЛОР-органов при ВИЧ
Длительное время персистенция ВИЧ в организме никак не проявляется. Симптомы иммунодефицита и заболевания ЛОР-органов развиваются примерно спустя 7-10 лет после инфицирования. Стадия первичных проявлений имеет две формы: гриппоподобную и мононуклеозоподобную. Чаще встречается второй вариант, который характеризуется лихорадкой, тонзиллитом, гепатоспленомегалией, генерализованной лимфденопатией, болью в суставах и отдельных группах мышц, диареей, иногда – макулопапулезной сыпью на туловище. При гриппоподобной форме наблюдается внезапное повышение температуры тела, озноб, ярко выраженная интоксикация, анорексия, полиаденопатия, экссудативный фарингит. Возникающие далее симптомы напрямую зависят от СПИД-ассоциированной патологии.
Наиболее частое заболевание при ВИЧ-инфекции – кандидоз носоглотки, наружного уха. Обычно они проявляются зудом в ухе, формированием ангулита, выделением бело-серых масс творожистой консистенции с неприятным запахом, иногда – с примесью крови, кондуктивной тугоухостью, выраженным увеличением шейных, поднижнечелюстных лимфоузлов, нарастанием общей интоксикации организма. Патологические изменения ЛОР-органов при гистоплазмозе включают в себя глубокие эрозии в носоглотке, ротоглотке и на небе, сопровождающиеся выраженной болью при глотании. Реже язвы формируются на коже наружного носа или ушей. Визуально они имеют бугристую поверхность с приподнятыми краями. Местные проявления сочетаются с резким повышением температуры до 39,0-40,5° C, признаками поражения легких, печени, селезенки.
Бактериальные поражения при ВИЧ-инфекции характеризуются быстрым развитием тяжелого интоксикационного синдрома и выраженных классических симптомов, типичных для поражения того или иного органа, чаще всего – носоглотки, придаточных пазух носа, слуховой трубы, среднего уха. Наблюдаются тяжелые обострения уже имеющихся хронических форм ЛОР-заболеваний. Герпес-вирусная инфекция при СПИДе сопровождается появлением на слизистой оболочке полости рта, ротоглотки, зева, коже ушных раковин и наружного носа групп везикул. Внешне они представляют собой небольшие пузырьки, заполненные серозной или серозно-гнойной жидкостью, проявляются зудом, умеренной болезненностью покалывающего характера. Спустя 2-5 дней везикулы высыхают, на их поверхности формируются сухие корки. Иногда отдельные элементы сыпи сливаются в одну многокамерную структуру, которая после вскрытия оставляет глубокую эрозию.
При опоясывающем лишае обнаруживаются аналогичные высыпания, образующиеся по ходу верхнечелюстной и нижнечелюстной ветвей тройничного нерва, зачастую – только с одной стороны. Жалобы пациента при этом дополняются острой локальной болью невралгического характера, парестезиями. Герпетическая лихорадка возникает внезапно. Первыми признаками являются озноб, повышение температуры до 40,0° C, разлитая головная боль с менингеальными симптомами, редко – бред. Через 1,5-3 дня от начала заболевания общее состояние больного несколько улучшается, в области носа и вокруг рта появляется герпетическая сыпь. При синдроме Ханта вирус герпеса поражает ганглий коленца, что сопровождается резким ухудшением слуха, болевым синдромом с эпицентром в области слухового канала, иррадиацией в затылочный и скуловой участки, герпетической сыпью на ушной раковине и в полости наружного уха.
Очаги саркомы Капоши располагаются асимметрично на поверхности глотки, гортани, ротовой полости, лица, раковин наружного уха и заушных складок. Первичные элементы на слизистых оболочках представляют собой узлы темно-синего, темно-красного цвета. Далее образуются болезненные синюшные, бурые или черные пятна, которые быстро увеличиваются в диаметре, трансформируются в язвы. Возникает нарушение акта глотания, осиплость голоса. На кожных покровах часто образуются папулы и бляшки коричневого цвета, склонные к слиянию и изъязвлению.
Бактериальные и грибковые поражения при ВИЧ-инфекции склонны к быстрому распространению из первичного очага в полости других ЛОР-органов с развитием абсцессов носовой перегородки, фронтитов, гайморитов, этмоидитов, сфеноидитов, евстахиитов, наружных и средних гнойных отитов, лабиринтитов, фарингитов и ларингитов. При отсутствии адекватного лечения инфекция проникает в полость черепа, вызывая формирование внутричерепных и системных осложнений – гнойного менингита, энцефалита, абсцессов головного мозга, тромбофлебита кавернозного синуса, флегмоны орбиты, пневмоний, сепсиса и других. Поражение гортани и глотки при саркоме Капоши может сопровождаться обильными кровотечениями из участков изъязвлений, присоединением вторичной инфекции.
Диагностика поражений ЛОР-органов при иммунодефиците требует комплексного анализа анамнеза, жалоб, данных физикального исследования, общих и специфических лабораторных тестов. Последние играют решающую роль при постановке диагноза. Полная программа обследования больного с подозрением на ВИЧ предусматривает:
- Опрос пациента. При беседе с больным отоларинголог акцентирует внимание на эпидемиологическом анамнезе, давности и характере парентеральных манипуляций, других потенциальных рисках инфицирования ВИЧ. При сборе жалоб устанавливается последовательность их возникновения, наличие беспричинных лихорадок, диарей, колебаний массы тела.
- Физикальное обследование. При общем осмотре определяется выраженное увеличение регионарных лимфатических узлов на фоне умеренной генерализованной лимфаденопатии. При герпес-инфекции на коже лица присутствует специфическая кожная сыпь, которая при опоясывающем лишае распространяется строго по ходу веток тройничного нерва.
- Осмотр ЛОР-органов. При подозрении на ВИЧ-инфекцию проводится полный отоларингологический осмотр, включающий отоскопию, переднюю и заднюю риноскопию, мезофарингоскопию, непрямую ларингоскопию. Эти методики позволяют визуализировать гиперемию и отечность слизистых оболочек, наличие специфических налетов, высыпаний или изъязвлений той или иной анатомической области.
- Рутинные лабораторные тесты. В ОАК при бактериальных и микозных инфекциях присутствует слабовыраженный нейтрофильный лейкоцитоз или лимфоцитопения, повышение СОЭ, при вирусных – лимфоцитоз и/или моноцитоз. На фоне ВИЧ-инфекции определяются атипичные мононуклеары, падение уровня тромбоцитов и гемоглобина.
- Специфические исследования крови. Для подтверждения СПИДа применяются серологические методы диагностики, позволяющие выявить специфические антитела к ВИЧ: иммуноблоттинг, иммуноферментный анализ. Также используется методика полимеразной цепной реакции, которая идентифицирует вирусную РНК, позволяет оценить ее количество в периферической крови.
Лечение поражения ЛОР-органов при ВИЧ
Лечение нацелено на угнетение репликации ВИЧ и купирование оппортунистических инфекций. Комбинации препаратов подбираются с учетом состояния больного и развившихся патологий ЛОР-органов. Терапевтическая программа включает:
- Антиретровирусную терапию. Для подавления активности вируса используются нуклеозидные и ненуклеозидные ингибиторы обратной транскриптазы, ингибиторы протеазы, ингибиторы фузии в различных комбинациях.
- Этиотропную терапию. При герпетических поражениях назначаются противовирусные препараты из группы ацикловира. При бактериальных заболеваниях показаны высокие дозы антибиотиков широкого спектра действия – аминопенициллинов, цефалоспоринов 3-4 поколения, фторхинолонов, карбопенемов. При грибковых патологиях применяются антимикотические препараты – производные имидазола.
- Патогенетическое и симптоматическое лечение. Заключается в дезинтоксикационной терапии с использованием плазмозаменителей, введении внутривенных иммуноглобулинов, препаратов крови, общеукрепляющих средств, противовоспалительных, антигистаминных и обезболивающих медикаментов, витаминных комплексов.
Прогноз относительно поражений ЛОР-органов на фоне дефицита иммунитета – сомнительный. Ранняя диагностика и хороший ответ организма пациента на фармакотерапию позволяют купировать заболевания или перевести их в хроническую форму. Прогноз для непосредственно ВИЧ-инфекции – неблагоприятный. В современных условиях заболевание неизлечимо, но антиретровирусные препараты дают возможность контролировать репликацию вируса, существенно увеличить продолжительность и улучшить качество жизни больного. Первичная профилактика оппортунистических заболеваний ЛОР-органов основывается на предотвращении инфицировании ВИЧ, вторичная - на соблюдении принципов антиретровирусной терапии, регулярных профилактических осмотрах у лечащего врача.
ОБЕСПЕЧЕНИЕ БЕЗОПАСНОСТИ ПРИ ОКАЗАНИИ СТОМАТОЛОГИЧЕСКОЙ ПОМОЩИ ВИЧ-АССОЦИИРОВАННЫМ ПАЦИЕНТАМ
Пандемия ВИЧ/СПИД представляет собой одну из сложнейших проблем, стоящую перед человечеством в настоящее время. Масштабы ее распространения приобрели глобальный характер и представляют реальную угрозу развитию большинству стран мира.
Распространение ВИЧ-инфекции не только не ослабевает, но и продолжает развиваться и усиливаться, что подтверждают экспертные оценки Объединенной программы ООН по ВИЧ/СПИД (ЮНЭЙДС) и Всемирной организации здравоохранения (ВОЗ). В условиях генерализованной эпидемии ВИЧ-инфекции в России возрастает риск инфицирования ВИЧ стоматологического персонала в результате аварийных ситуаций при выполнении профессиональных обязанностей. В связи с этим профилактика профессионального заражения ВИЧ-инфекцией медицинских работников остается актуальной и социально значимой.
Оказание стоматологической помощи ВИЧ-ассоциированному пациенту должно осуществляться с необходимыми мерами предосторожности и при неукоснительном выполнении правил дезинфекции и стерилизации. Только так можно избежать заражения по цепочке пациент — врач — пациент, инфицирования вспомогательного медперсонала, внутрибольничного распространения инфекции.
Лечение стоматологических заболеваний у больных СПИДом носит традиционный характер и проводится в обычных поликлинических условиях. Вероятность контакта с ВИЧ при оказании стоматологической помощи невелика, порядка 0,85 %, тем не менее стоматологов относят к профессиональной группе риска наряду с некоторыми другими специалистами-медиками. Известно, что у ВИЧ-инфицированных пациентов на фоне вторичного иммунодефицита активируется условно-патогенная флора, способствующая развитию оппортунистических заболеваний.
Установлено, что наиболее ранний и обязательный манифестный признак ВИЧ-инфекции — проявления в полости рта. Так, к числу ранних широко распространенных ВИЧ-индикаторных оральных заболеваний относят ВИЧ-ассоциированные заболевания пародонта, которые характеризуются довольно стойким длительным течением и резистентностью к общепринятым методам лечения. Клиническим признаком ВИЧ-пародонтита служит быстропрогрессирующая деструкция альвеолярной кости и периодонтальной ткани, сопровождающаяся воспалением, болезненностью и спонтанными десневыми кровотечениями.
Ближайшие события
Присоединение грибковой инфекции способствует развитию резистентности к общепринятым средствам местного лечения, что приводит к усилению и сохранению воспалительного процесса в полости рта. При ортопедическом лечении воспаление слизистой оболочки десен способно существенно усложнить процесс препарирования зуба под коронку, особенно создание уступа, снятие двойного оттиска силиконовыми массами, подгонку и фиксацию мостовидного протеза. Эти осложнения в итоге приводят к снижению качества протезирования. Кроме того, значительное кровотечение десны при пародонтите у ВИЧ-инфицированного пациента может привести к вирусной контаминации оттиска и протеза на промежуточных этапах, что может создавать опасность инфицирования для врача и зубного техника.
Основную опасность для врача-стоматолога представляет загрязнение кожи, слизистой оболочки глаз, рта, носа, инфицированной кровью или другими биожидкостями пациента. При этом, например, ротовая жидкость (слюна) считается малоопасной, так как содержание в ней ВИЧ у больного СПИДом ничтожно мало по отношению к содержанию вируса в крови. Риск заражения возрастает при повреждении кожи рук острыми борами, дрилями, корневыми или инъекционными иглами.
Следует твердо помнить: любой пациент может быть носителем вируса. Поэтому все манипуляции в полости рта при работе с каждым пациентом всегда должны проводиться с использованием «барьерных средств»: перчаток, маски, очков, халата.
Доказано, что в стоматологии, где большинство манипуляций носит инвазивный характер, передача вируса иммунодефицита человека наряду с другими инфекционными агентами может происходить и при использовании нестерильных игл, шприцев, боров, эндодонтических и прочих инструментов. Более того, ВИЧ, например, не погибает в результате протирания инструмента ваткой, смоченной спиртом. Поэтому сепарационные металлические диски, кроме алмазного, являются одноразовыми, и их следует выбрасывать после каждого приема пациента.
Возбудитель ВИЧ/СПИД высокочувствителен к нагреванию. При кипячении погибает в течение 2—3 минут. В то же время вирус устойчив к действию ультрафиолетового и гамма-излучения в дозах, обычно применяемых при стерилизации. Хлорсодержащие дезинфектанты (2—3%-ный раствор хлорамина, 3%-ный раствор хлорной извести) в обычно применяемых концентрациях инактивируют вирус в течение 10—20 минут. Во внешней среде вирус относительно неустойчив. В крови на предметах в нативном состоянии сохраняет заразную способность в течение 14 дней, в высушенных субстратах — до 7 суток.
Эффективная профилактика ВИЧ-инфицирования пациента и медработника в зубоврачебном кабинете и зуботехнической лаборатории возможна и должна осуществляться при строгом соблюдении правил дезинфекции и стерилизации.
Основными нормативными документами, регламентирующими санитарно-противоэпидемический режим в стоматологическом кабинете, являются:
Федеральный закон РФ «Об основах охраны здоровья граждан в Российской Федерации» от 21.11.2011 г. № 323-ФЗ;
Федеральный закон РФ «О санитарно-эпидемиологическом благополучии населения» от 30.03.1999 г. № 52-ФЗ;
СанПиН 2.1.3.2630-10 «Санитарно-эпидемиологические требования к организациям, осуществляющим медицинскую деятельность»;
СанПиН 2.1.7.2790-10 «Санитарно-эпидемиологические требования к обращению с медицинскими отходами»;
СанПин 3.1.1.2341-08 «Профилактика вирусного гепатита В»;
СанПин 3.1.5.2826-10 «Профилактика ВИЧ-инфекции»:
8.3. Профилактика профессионального инфицирования ВИЧ.
8.3.3.1. Действия медицинского работника при аварийной ситуации:
– в случае порезов и уколов немедленно снять перчатки, вымыть руки с мылом под проточной водой, обработать руки 70%-ным спиртом, смазать ранку 5%-ным спиртовым раствором йода;
– при попадании крови или других биологических жидкостей на кожные покровы это место обрабатывают 70%-ным спиртом, обмывают водой с мылом и повторно обрабатывают 70%-ным спиртом;
– при попадании крови и других биологических жидкостей пациента на слизистую глаз, носа и рта ротовую полость следует промыть большим количеством воды и прополоскать 70%-ным раствором этилового спирта, слизистую оболочку носа и глаза обильно промыть водой (не тереть);
– при попадании крови и других биологических жидкостей пациента на халат, одежду нужно снять рабочую одежду и погрузить в дезинфицирующий раствор или в бикс (бак) для автоклавирования;
– как можно быстрее начать прием антиретровирусных препаратов в целях постконтактной профилактики заражения ВИЧ.
Рекомендуется использовать аптечку «Анти-СПИД».
С целью экстренной профилактики ВИЧ-инфекции назначается азидотимидин в течение 1 месяца. Сочетание азидотимидина (ретровир) и ламивудина (эливир) усиливает антиретровирусную активность и преодолевает формирование резистентных штаммов.
При высоком риске заражения ВИЧ-инфекцией (глубокий порез, попадание видимой крови на поврежденную кожу и слизистые от пациентов, инфицированных ВИЧ) для назначения химиопрофилактики следует обращаться в территориальные центры по борьбе и профилактике СПИД.
Лица, подвергшиеся угрозе заражения ВИЧ-инфекцией, находятся под наблюдением врача-инфекциониста в течение 1 года с обязательным обследованием на наличие маркера ВИЧ-инфекции.
Необходимо в возможно короткие сроки после контакта обследовать на ВИЧ и вирусные гепатиты B и C лицо, которое может являться потенциальным источником заражения, и контактировавшее с ним лицо. Обследование на ВИЧ потенциального источника ВИЧ-инфекции и контактировавшего лица проводят методом экспресс-тестирования на антитела к ВИЧ после аварийной ситуации с обязательным направлением образца из той же порции крови для стандартного тестирования на ВИЧ в ИФА. Образцы плазмы (или сыворотки) крови человека, являющегося потенциальным источником заражения, и контактного лица передают для хранения в течение 12 месяцев в центр СПИД субъекта Российской Федерации. Пострадавшего и лицо, которое может являться потенциальным источником заражения, необходимо опросить о носительстве вирусных гепатитов, ИППП, воспалительных заболеваний мочеполовой сферы, других заболеваний, провести консультирование относительно менее рискованного поведения. Если источник инфицирован ВИЧ, выясняют, получал ли он антиретровирусную терапию. Если пострадавшая — женщина, необходимо провести тест на беременность и выяснить, не кормит ли она грудью ребенка. При отсутствии уточняющих данных постконтактную профилактику начинают немедленно, при появлении дополнительной информации схема корректируется.
Проведение постконтактной профилактики заражения ВИЧ антиретровирусными препаратами:
Прием антиретровирусных препаратов (рис. 1.) должен быть начат в течение первых двух часов после аварии, но не позднее 72 часов.
Стандартная схема постконтактной профилактики заражения ВИЧ — лопинавир/ритонавир + зидовудин/ламивудин. При отсутствии данных препаратов для начала химиопрофилактики могут использоваться любые другие антиретровирусные препараты; если невозможно сразу назначить полноценную схему высокоактивной антиретровирусной терапии (ВААРТ), начинается прием одного или двух имеющихся в наличии препаратов.
Использование невирапина и абакавира возможно только при отсутствии других препаратов. Если единственным из имеющихся препаратов является невирапин, должна быть назначена только одна доза препарата — 0,2 г (повторный его прием недопустим), затем при поступлении других препаратов назначается полноценная химиопрофилактика. Если химиопрофилактика начата с использованием абакавира, следует как можно быстрее провести исследование на реакцию гиперчувствительности к нему или провести замену абакавира на другой НИОТ. Все работники медицинских учреждений должны знать о профессиональном риске инфицирования и осознавать необходимость соблюдения универсальных мер предосторожности при работе со всеми пациентами, в любых ситуациях, независимо от диагноза. Весь персонал медицинских учреждений в рамках последипломного повышения квалификации должен регулярно проходить тематические циклы усовершенствования по проблеме ВИЧ/СПИДа и инструктаж по технике безопасности. Обучение универсальным мерам предосторожности должно быть также обязательной частью инструктажа медицинских работников при приеме на работу. Профилактика ВИЧ/СПИДа в стоматологии предусматривает выявление группы риска, анамнестических данных, тщательную стерилизацию инструментария.
При работе в стоматологическом кабинете необходимо соблюдать следующие меры:
1. Использование средств индивидуальной защиты (халат, маска, перчатки, защитные очки и экран, нарукавники, непромокаемые фартуки).
2. Использование одноразового инструментария всюду, где это возможно (слюноотсосы, пылесосы, одноразовые карпульные шприцы и т. д.).
3. Централизованная стерилизация медицинского инструментария с контролем эффективности.
4. Врачи с экссудативными поражениями кожи не должны выполнять инвазивных процедур.
5. Медицинский работник должен относиться к крови и к другим биологическим жидкостям организма как к потенциально заразному материалу.
6. Соблюдать осторожность при работе с колющимися и режущими предметами (иглы, скальпели, ножницы, эндодонтический инструментарий).
7. Использовать систему коффердам, слюноотсосы, пылесосы. Соблюдать правила эргономики.
8. В ортопедической стоматологии все ортопедические изделия промываются как после изъятия из полости рта пациента перед отправкой в зуботехническую лабораторию, так и перед установкой в полости рта. В связи с увеличением числа используемых стоматологических инструментов для каждого вида их должен быть отработан и использоваться свой режим стерилизации и дезинфекции.
9. Стоматологическое оборудование и поверхности, трудно дезинфицируемые (рентгенологическая аппаратура и др.), которые в процессе работы могут быть контаминированы, заворачиваются в непромокаемые материалы (к примеру, пластиковые конверты) для их защиты. Этот защитный слой должен, естественно, заменяться после каждого пациента.
Таким образом, при оказании медицинской помощи, особенно стоматологической, имеется высокий риск инфицирования ВИЧ-инфекцией. В этой связи необходим постоянный мониторинг случаев внутрибольничного инфицирования как пациентов, так и медицинского персонала. Необходимо повысить соблюдение контроля над выполнением рекомендаций по инфекционной безопасности при оказании стоматологических медицинских услуг.
Читайте также:
